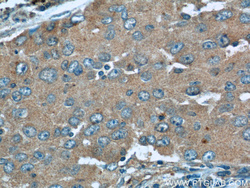

Antibody data
- Antibody Data
- Antigen structure
- References [2]
- Comments [0]
- Validations
- Western blot [1]
- Immunohistochemistry [1]
Submit
Validation data
Reference
Comment
Report error
- Product number
- 11538-1-AP - Provider product page

- Provider
- Proteintech Group
- Proper citation
- Proteintech Cat#11538-1-AP, RRID:AB_10699869
- Product name
- TUSC2 antibody
- Antibody type
- Polyclonal
- Description
- TUSC2 antibody (Cat. #11538-1-AP) is a rabbit polyclonal antibody that shows reactivity with human, mouse, rat and has been validated for the following applications: IF, IHC, WB, ELISA.
- Reactivity
- Human, Mouse, Rat
- Host
- Rabbit
- Conjugate
- Unconjugated
- Isotype
- IgG
- Vial size
- 20ul, 150ul
Submitted references NEDD4 degrades TUSC2 to promote glioblastoma progression.
TWIST1/miR-584/TUSC2 pathway induces resistance to apoptosis in thyroid cancer cells.
Rimkus TK, Arrigo AB, Zhu D, Carpenter RL, Sirkisoon S, Doheny D, Regua AT, Wong GL, Manore S, Wagner C, Lin HK, Jin G, Ruiz J, Chan M, Debinski W, Lo HW
Cancer letters 2022 Apr 10;531:124-135
Cancer letters 2022 Apr 10;531:124-135
TWIST1/miR-584/TUSC2 pathway induces resistance to apoptosis in thyroid cancer cells.
Orlandella FM, Di Maro G, Ugolini C, Basolo F, Salvatore G
Oncotarget 2016 Oct 25;7(43):70575-70588
Oncotarget 2016 Oct 25;7(43):70575-70588
No comments: Submit comment
Supportive validation
- Submitted by
- Proteintech Group (provider)
- Main image

- Experimental details
- human heart tissue were subjected to SDS PAGE followed by western blot with 11538-1-AP(TUSC2 antibody) at dilution of 1:300
- Sample type
- tissue
Supportive validation
- Submitted by
- Proteintech Group (provider)
- Main image
- Experimental details
- The TUSC2 antibody from Proteintech is a rabbit polyclonal antibody to a recombinant protein of human TUSC2. This antibody recognizes human,mouse,rat antigen. The TUSC2 antibody has been validated for the following applications: ELISA, WB, IHC analysis.